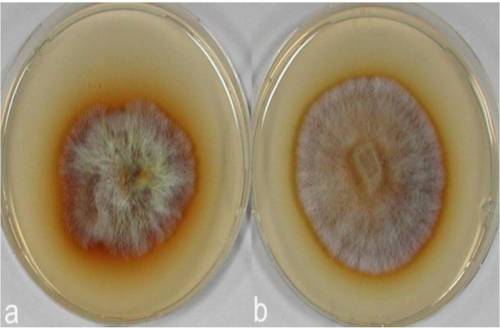
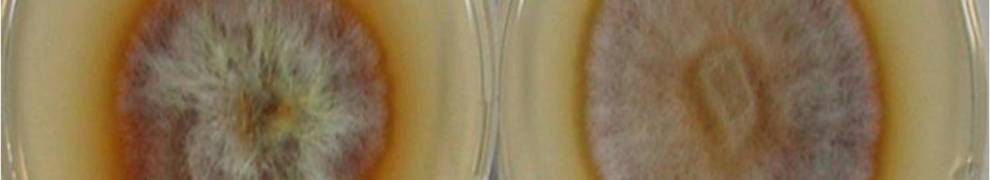
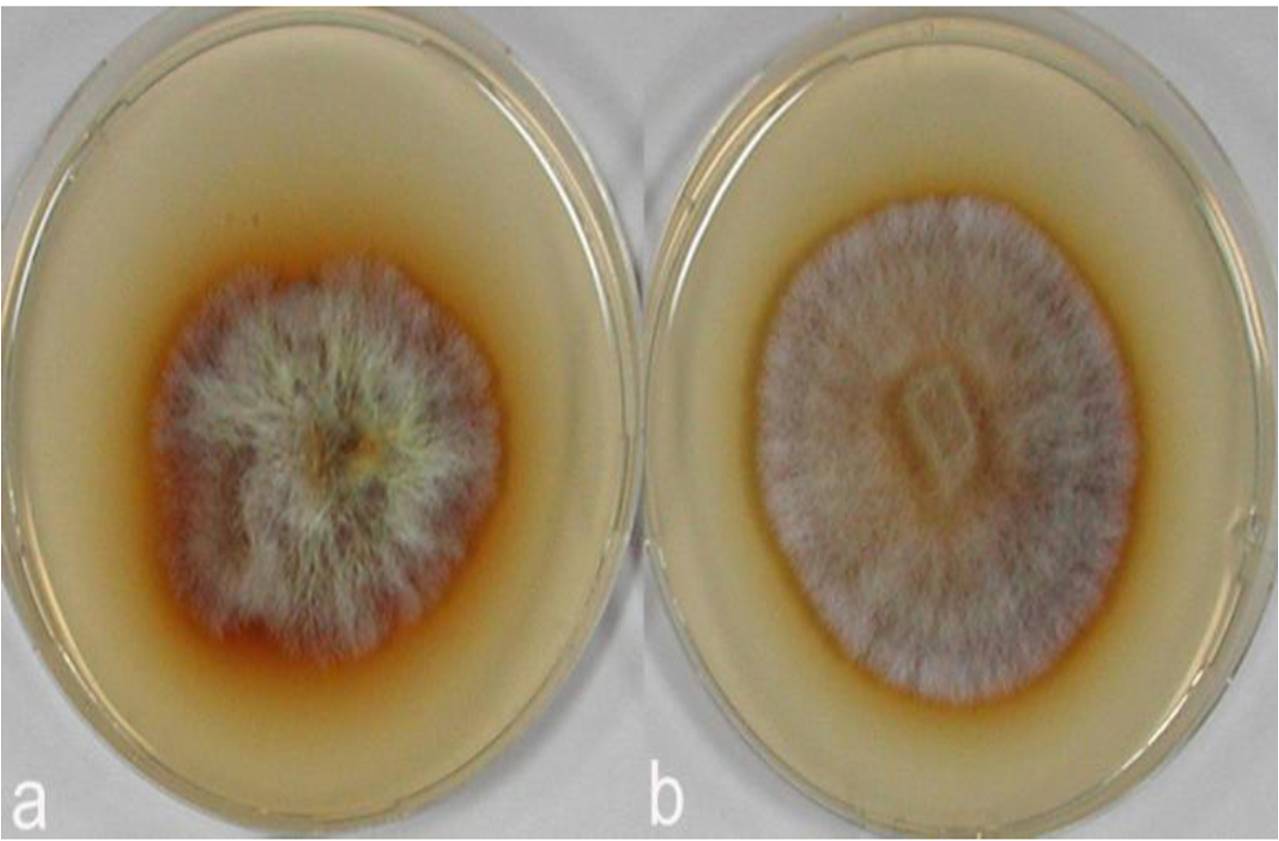

[TomVolkFungi.net]
[TomVolkFungi.net]
Metode untuk menentukan tipe pelapukan kayu oleh jamur dikembangkan 83 tahun yang lalu oleh Bavendamm (1928) dan diterbitkan di jurnal Pflanzenschutz, karena itu test ini sering disebut dengan Bavendamm Test dan media untuk mengujinya sering disebutkan hanya dengan nama media Bavendamm. Saya tidak bisa mendapatkan literatur aslinya dan tidak tahu bahasanya juga. Cuma uji ini sudah sangat umum digunakan untuk determinasi fungi pelapuk putih atau fungi pelapuk coklat. Ada beberapa literatur tahun 50-an dan 70-an yang menyebutkannnya. Metode ujinya sangat sederhana, mudah, cepat, dan akurat (terima kasih Pak Bavendamm yang telah menemukan metode ini).
Untuk mengenali apakah fungi atau jamur itu termasuk fungi pelapuk putih atau bukan, pertama, tentukan terlebih dahulu jamur tersebut termasuk Basidiomycetes atau bukan. Cara mudah membedakan basidiomycetes adalah dengan melihat tubuh buahnya. Umumnya basidiomycetes adalah jamur makro dan bisa membentuk tubuh buah. Memang ada beberapa jamur pelapuk putih yang tidak membentuk tubuh buah, seperti Phanerochaete chrysosporium. Di bawah mikroskop, miselia basidiomycetes juga terlihat lebih besar daripada jamur Ascomycetes atau Deuteromycetes.
Sepanjang pengetahuan saya, para ahli sepakat jika fungi pelapuk putih dan fungi pelapuk coklat berasal dari kelompok Basidiomycetes. Jadi rasanya aneh bin tidak lazim kalau ada yang mengatakan fungi pelapuk putih, tetapi jamurnya dari kelompok Ascomycetes, apalagi Deuteromycetes.
Setelah yakin kalau jamurnya adalah basidio, baru kita test dengan media Bavendamm. Media Bavendamm adalah media jamur yang umum (PDA atau MEA) yang diberi tambahan Tannic acid, Galic Acid, Guaiacol, atau lignin. Konsentrasinya bermacam-macam, ada yang menyebutkan 0,05%-1,5%. Saya seringnya pakai Galic acid atau Guaiacol sebanyak 1%. Arora et al (1985) dan Choi et al (2005) menambahkan 0,05% asam tanik pada media MEA.
Setelah media disiapkan, jamur kita inokulasikan ke cawan yang sudah berisi media Bavendamm. Jamur ditumbuhkan di tempat gelap, kalau bisa pakai inkubator pada suhu 25oC selama seminggu. Koloni jamur akan tumbuh. Nah, amati bagian bawah media agar tersebut. Kalau medianya terbentuk warna coklat disekeliling koloni, berarti uji Bavendammnya positif (+). Artinya, jamur tersebut bisa mengoksidasi tannin, asam galic atau guaiacol. Dan jamur ini bisa dikelompokkan ke dalam jamur pelapuk putih.
 [Badalyan]
[Badalyan]
Kalau hasil test Bavendamm-nya negatif, di bagian bawah koloni tidak terbentuk warna coklat. Berarti jamur tersebut bukan termasuk kelompok jamur pelapuk putih, tetapi jamur pelapuk coklat.
Metode pengujian qualitatif lignocellolytic enzyme yang dihasilkan oleh jamur dijelaskan secara detail oleh Stephen B. Pointing (1999). Pointing menjelaskan berbagai macam metode salah satunya Bavendamm test, dan penggunaan pewarna lainnya.
Artikel saya tentang pemanfaatan jamur pelapuk putih:
BIOLOGICAL PRETREATMENT OF LIGNOCELLULOSES WITH WHITE-ROT FUNGI AND ITS APPLICATIONS: A REVIEW
Bavendamm, W. 1928. Über das Vorkommen und den Nachweis von Oxydasen bei holzzerastörenden Pilzen. Z. -Pfanzenkrankh. Pfanzenschutz 38, 257-276
Pointing S.B. (1999). Qualitative methods for the determination of lignocellulolytic enzyme
production by tropical fungi. Fungal Diversity 2: 17-33.

Pingback: Uji Bavendamm Beberapa Isolat Fungi | Berbagi Tak Pernah Rugi
Pingback: Fungi Pelapuk Putih dan Fungi Pelapuk Coklat | Berbagi Tak Pernah Rugi
pak isroi, saya ingin berternak jamur, tapi pengetehauanku tentang jamur sangat minim sekali, kalau saya boleh tanya,
1. Dimana saya bisa memperoleh bibit jamur tiram?
2. Bagaimana cara berternak jamur yang benar?
Lokasi saya di daerah brondong-lamongan-jatim
Bibit jamur banyak yang jual, tanya Om Google dengan kata kunci bibit jamur tiram. Di toko buku juga banyak buku yang menjelaskan bagaimana cara bertanam jamur. Macam-macam jamur.
Pak, bisa minta referensi buku panduan identifikasi fungi?
Yang ada identifikasi Pleurotus, Phanerochaete, dll. Coba cek dibposting lain. Atau cari dg kotak pencarian, pakai kata kunci identifikasi..
pak, dimana saya bisa cari atau beli asam galat ???
di toko bahan kimia, seperti bratachem atau yang lainnya. Selain asam galat bisa juga diganti dengan tanic acid atau asam tanin.
bratachem ada di daerah mana tokonya pak ??
apa menerima pengiriman keluar kota ??
karna saya butuh sekali…
Saya rasa di setiap kota besar atau kota yang ada universitas negerinya ada Bratachem. Coba tanya om google…
kalo as. galat nya diganti dengan tanin acid ato asam tanin takaran masih tetap sama pak ???
Sama saja takarannya
thanx pak..
assalamualaikum……..
untuk jenis exidia, dan exidiopsis apakah termasuk fungi pelapuk putih….?
bisa tolong berikan informasi untuk fungi2 yang tergolong jenis fpp.
terimakasih sebelumnya.
Kan sudah saya buat daftarnya, coba cek di posting yang lain tentang JPP, gunakan fasilitas pencarian yang ada di atas.
penggunaan pelapuk putih pada fermensi jerami,atau bahan pakan yang lain itu seperti ap dong???….
tolong dong……………………..
coba baca-bacaa postingan saya yang lain tentang jamur pelapuk putih.
pak kalau saya mau beli guaiacol, veratril alkohol, ABTS, dll yang diperlukan untuk uji aktifitas enzim ligninolitik, saya bisa pesan dimana ya pak, terima kasih sebelumnya…
beli di toko kimia, misalnya Bratachem….
mau nanya Pak. Jamur pelpauk kayu itu lebih cepat tumbuh pada substrat kayu yg mengandung kadar lignin yg tinggi atau yg rendah? mhon penjelasannya pak
tergantung jamurnya. Ada yang suka yang banyak ligninnya ada yang suka yang banyak selulosanya.
pak saya imam chanif mahasiswa sebuah universitas di malang. pak saya ingin bertanya fungsi uji bavendam untuk mengetahui jamur tersebut merupakan JPP. yang dalam hal ini hubungannya dengan degradasi lignin?
mohon pencerahannya pak. terima kasih.
Uji bavendam memang digunakan untuk menguji apakah jamur tertentu termasuk JPP atau bukan dan menghasilkan enzyme ligninolitik atau tidak.
pak saya mau tanya. kenapa uji potensi ligninolitik itu memakai asam tanin? terimakasih
Tanin digunakan sebagai model pengganti lignin. Mekanisme degradasi tanin mirip dengan lignin, karena itu digunakan tanin sebagai substrate.